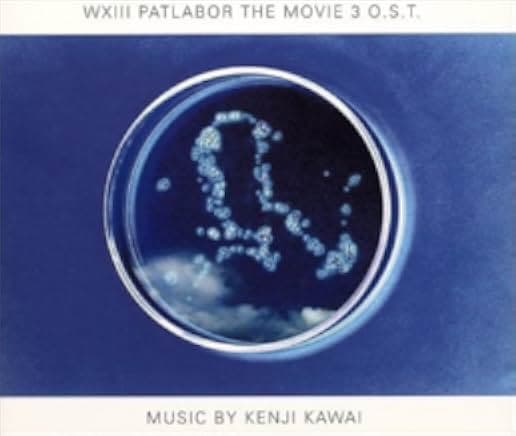
WXIII: Patlabor the Movie 3 2002

6در حوالی خلیج توکیو قتل های مرموزی در حال رخ دادن است. از این رو 2 کاراگاه با نام های شینیچیرو هاتا و تاسمی کوسومی مامور میشوند تا تحقیقات خود را آغاز نماییند. پس از گذشت مدتی آنها پی میبرند این حملات مربوط به ارتش امریکا است که در ژاپن مستقر هستند و بر روی پروژه ای با نام واستید 13 کار میکنند. اما ...
Two police detectives and SV2 investigate a series of mysterious acts of deadly destruction occuring in and around Tokyo Bay.
فیلم WXIII: Patlabor the Movie 3 2002 محصول سال 2002 ساخته Takuji Endo, Fumihiko Takayama با بازی بازیگران Atsuko Tanaka, Katsuhiko Watabiki, Hiroaki Hirata در ژانر انیمیشن, علمی تخیلی, اکشن, جرم ساخته شده است.
با ورود به سایت میتوانید این فیلم را مشاهده کنید.